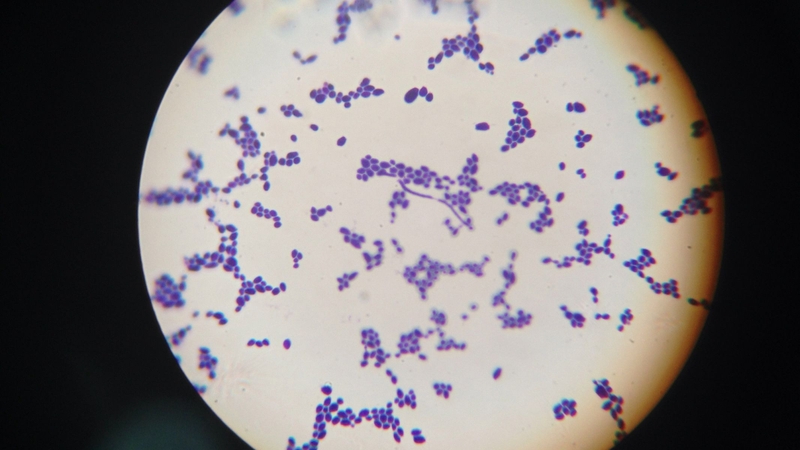
Xịt sản phẩm lên quần lót còn ẩm làm cho vi khuẩn và nấm phát triển

Tốt nghiệp đại học Khoa Dược. Có kinh nghiệm hơn 10 năm trong lĩnh vực Dược phẩm, tư vấn thuốc và thực phẩm chức năng. Hiện đang là giảng viên cho Dược sĩ tại Nhà thuốc Long Châu.
Ngọc Vân
17/03/2026
Mặc định
Lớn hơn
Nước hoa vùng kín nữ được nhiều chị em lựa chọn để giúp cơ thể luôn thơm mát và tự tin hơn trong sinh hoạt hằng ngày. Vì vậy, việc hiểu rõ cách sử dụng nước hoa vùng kín nữ an toàn, đúng cách sẽ giúp bạn bảo vệ sức khỏe và hạn chế những rủi ro không mong muốn.
Giữ cho vùng kín luôn thơm tho, dễ chịu là mong muốn của nhiều phụ nữ, đặc biệt trong những ngày vận động nhiều hoặc thời tiết nóng bức. Nước hoa vùng kín nữ vì thế trở thành sản phẩm được quan tâm trong thời gian gần đây. Tuy nhiên, để đảm bảo an toàn cho sức khỏe, chị em cần biết cách sử dụng đúng cách, lựa chọn sản phẩm phù hợp và tránh những sai lầm phổ biến có thể gây ảnh hưởng đến vùng da nhạy cảm.
Nước hoa vùng kín là sản phẩm chăm sóc cá nhân được thiết kế nhằm tạo mùi thơm nhẹ và mang lại cảm giác dễ chịu cho khu vực cơ quan sinh dục ngoài của phụ nữ. Khác với nước hoa thông thường, sản phẩm này thường được bào chế với nồng độ hương liệu thấp, kết hợp các thành phần dịu nhẹ để hạn chế kích ứng đối với vùng da và niêm mạc nhạy cảm.
Nước hoa vùng kín thường tồn tại dưới dạng xịt hoặc dung dịch nhỏ giọt, sử dụng ngoài da nhằm hỗ trợ khử mùi tạm thời. Tuy nhiên, việc sử dụng cần thận trọng để tránh ảnh hưởng đến độ pH tự nhiên và hệ vi sinh tại vùng kín.

Vùng kín của phụ nữ có cấu trúc da và niêm mạc rất nhạy cảm, đồng thời tồn tại hệ vi sinh vật có lợi giúp duy trì độ pH sinh lý. Vì vậy, khi sử dụng nước hoa vùng kín, chị em cần áp dụng đúng cách để hạn chế nguy cơ kích ứng, mất cân bằng hệ vi khuẩn tự nhiên và các vấn đề viêm nhiễm phụ khoa.
Ưu tiên các sản phẩm có nguồn gốc rõ ràng, được kiểm nghiệm an toàn cho da nhạy cảm. Thành phần nên dịu nhẹ, hạn chế hương liệu tổng hợp, cồn, paraben hoặc các chất dễ gây kích ứng. Một số sản phẩm có chiết xuất từ thảo dược hoặc thành phần hỗ trợ khử mùi nhẹ nhàng thường được đánh giá phù hợp hơn với vùng da nhạy cảm.
Trước khi sử dụng, cần vệ sinh vùng kín sạch sẽ và lau khô bằng khăn mềm. Đối với dạng xịt, nên giữ khoảng cách khoảng 15-20 cm và xịt một lượng nhỏ lên vùng da bên ngoài. Với dạng dung dịch nhỏ giọt, chỉ nên nhỏ vài giọt lên quần lót hoặc vùng da ngoài âm hộ. Tránh tuyệt đối việc sử dụng trực tiếp lên niêm mạc hoặc đưa sản phẩm vào bên trong âm đạo.

Nước hoa vùng kín chỉ nên sử dụng khi thực sự cần thiết, chẳng hạn trong những ngày vận động nhiều hoặc thời tiết nóng ẩm. Lạm dụng sản phẩm có thể làm thay đổi độ pH sinh lý của vùng kín, từ đó làm tăng nguy cơ viêm nhiễm hoặc da bị kích ứng.
Mặc dù nước hoa vùng kín có thể giúp cải thiện mùi hương và mang lại cảm giác tự tin, nhưng việc sử dụng cần được cân nhắc kỹ lưỡng. Một số đối tượng có thể sử dụng an toàn, trong khi những người khác nên hạn chế để tránh mất cân bằng môi trường âm đạo hoặc gây kích ứng da.
Đối tượng có thể cân nhắc sử dụng nước hoa vùng kín là:
Đối tượng nên hạn chế hoặc không nên sử dụng là:

Nhiều người vẫn mắc phải các sai lầm phổ biến có thể làm tăng nguy cơ kích ứng, viêm nhiễm hoặc rối loạn môi trường vi sinh tại khu vực nhạy cảm này. Dưới đây là những sai lầm cần tránh khi sử dụng nước hoa vùng kín:
Nước hoa vùng kín là sản phẩm chăm sóc cá nhân có chứa các hợp chất tạo hương và thành phần kháng khuẩn nhẹ, giúp duy trì mùi hương dễ chịu và hỗ trợ kiểm soát mùi cơ thể. Tuy nhiên, nếu bảo quản không đúng cách, các hoạt chất tạo mùi có thể bị phân hủy, làm giảm hiệu quả sử dụng và ảnh hưởng đến chất lượng sản phẩm. Vì vậy, người dùng cần lưu ý một số nguyên tắc bảo quản sau:

Hy vọng bài viết trên đã giúp bạn đọc hiểu rõ cách sử dụng nước hoa vùng kín nữ an toàn cho sức khỏe cũng như những lưu ý quan trọng khi lựa chọn và bảo quản sản phẩm. Bên cạnh đó, chị em cũng nên chú ý vệ sinh cá nhân đúng cách và lựa chọn sản phẩm có nguồn gốc rõ ràng để hạn chế nguy cơ kích ứng hoặc ảnh hưởng đến sức khỏe phụ khoa.
Dược sĩ Đại họcNguyễn Thị Hồng Nhung
Tốt nghiệp đại học Khoa Dược. Có kinh nghiệm hơn 10 năm trong lĩnh vực Dược phẩm, tư vấn thuốc và thực phẩm chức năng. Hiện đang là giảng viên cho Dược sĩ tại Nhà thuốc Long Châu.